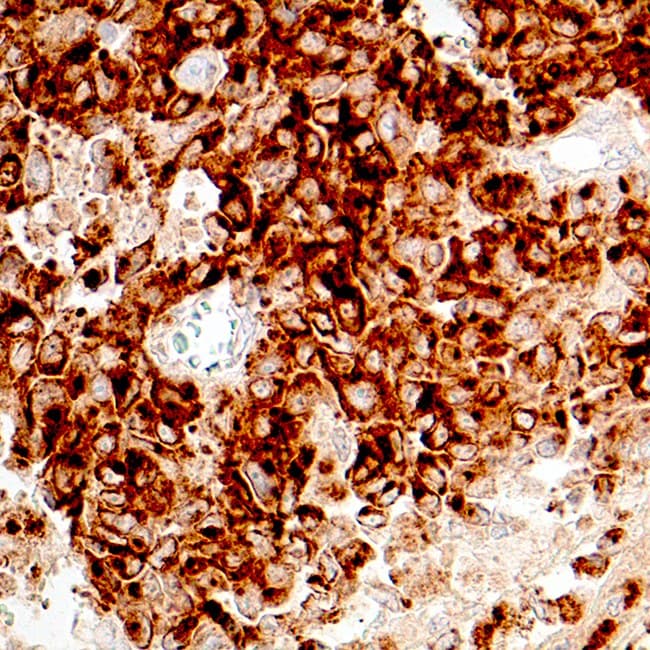

Anti-Tirosinasa CE/IVD para IHC - Dermopatología
La composición de la matriz extracelular de todos los vertebrados está dominada por una clase de moléculas conocidas como colágenos, cada una con una característica única adaptada a su función y localización. Se sabe que los colágenos tienen múltiples funciones. Intervienen en la diferenciación, morfogénesis y reparación de los tejidos; desempeñan un papel en el mantenimiento de la arquitectura de los tejidos; y forman la barrera de filtración de los vasos sanguíneos.
El Colágeno Tipo IV es un componente primario de la lámina basal que se utiliza como marcador para observar la presencia de la lámina y examinar su estructura. Además de la lámina basal epitelial, Anti-Collagen Type IV tiñe los componentes mesenquimales. Es útil para identificar cánceres de tejidos blandos, incluidos schwannomas y leiomiomas. El Anti-Colágeno Tipo IV reacciona frecuentemente con estos tejidos después de estar bien diferenciados y ser malignos. El uso de Anti-Collagen Type IV produce resultados más fiables que las tinciones de retículo de plata no específicas cuando se investigan los elementos vasculares de neoplasias, hemangiopericitoma, angiosarcoma y hemangioendotelioma epitelioide.

Sección de melanoma
Sección de melanoma
Resultados de su búsqueda : 4 Producto encontrado
Refine su búsqueda :
RUO
CE/IVD
NEW
- Unconjugated 4
- human 4
- mouse 4
- Primary antibody
- IHC 4
- T311 4
Referencia
Descripción
Cond.
Precio Sin IVA
‹
›
